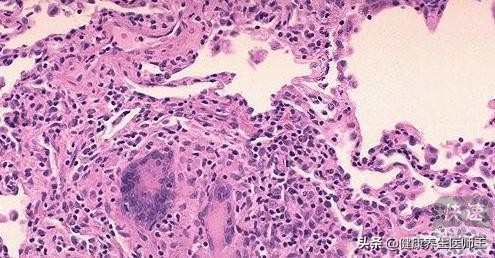
常见的肺间质疾病,常见血管疾病

常见肺部血管性疾病
肺的血管炎性疾病几乎均为全身性疾病的一部分,坏死性肉芽肿血管炎(Wegener肉芽 肿病) , Churg-Strauss综合征(CSS),显微镜下多血管炎(MPA)是最常见的累及肺部的血管炎性综合征。
其他偶见的累及肺部的血管炎性疾病还包括高安动脉炎、巨细胞性动脉炎、 贝赫切特病、结节性多动脉炎、过敏性紫癫、冷球蛋白血症。另外,可以出现血管壁炎症性改变的疾病还包括结缔组织病、淋巴瘤样肉芽肿、支气管中心性肉芽肿病、坏死性结节病样肉芽肿病、高血压,肺部感染性疾病、恶性淋巴瘤、药物性损伤及放疗后的肺部改变等。
由此可见,肺部的血管炎性疾病,病因复杂,常有肺外器官的异常表现,有时肺外表现及实验室检查是诊断的重要指标。甚至是判断预后的重要因素。因此,在肺部血管炎性疾病的诊断中,必须结合临床表现及实验室检查,这些资料对诊断非常重要,可以说是不可或缺的。主要讨论Wegener肉芽肿病、Churg-Strauss综合征和显微镜下多血管炎三种常见的肺部血管炎性疾病。

一、坏死性肉芽肿血管炎(Wegener)
Wegener肉芽肿(WG)是一种不明原因的系统性血管炎性疾病,现已改名为坏死性肉芽肿血管炎。可以发生于任何年龄,常见于成人,中位年龄为50岁。全身许多器官均可累及,如鼻、鼻窦、眼、耳、涎腺、口腔、肺、肾、关节、皮肤、乳腺、纵隔、胃肠道、膜腺、子宫、阴道、心脏、脾、外周和中枢神经系统。最常累及上呼吸道、肺和肾脏。
在鼻部引起坏死性炎症形成"马鞍鼻"。实验室检查60%~95%的WG患者有血清抗中性粒细胞胞质抗体(ANCA)阳性,常表现为C-ANCA阳性。这也是WG的重要诊断特征之一。
WG的肺部累及约占45%,临床表现为咳嗽、气促、咳血和胸痛。影像学表现为双肺多发性实变影,病灶大小不等,边界较清楚,下叶多见。病灶可呈游走性。25%~50%病灶中央可见空洞形成。 空洞的壁较厚,不规则。治疗后空洞壁可以变薄或空洞完全消失。
WG大体上表现为双肺多发性实变结节,灰黄色,常伴有地图状坏死。镜下可见肉芽肿性炎症,坏死和血管炎。典型的WG的坏死呈地图状、不规则,其内见较多的中性粒细胞及碎裂的细胞核,因此在HE染色上呈蓝染,也成为嗜碱性坏死。
坏死的周边部常见组织细胞呈栅栏状排列,和多核巨细胞及多种炎症细胞浸润。病变中一般不出现紧密排列的结节病样的上皮样细胞肉芽肿结节。WG病变中浸润的炎症细胞,成分混杂,可见中性粒细胞、淋巴细胞、浆细胞、组织细胞及嗜酸性粒细胞。
常见中性粒细胞聚集形成中性粒细胞微脓肿。WG的血管炎常累及大于5mm的小动脉和静脉。在病灶或坏死的周边部血管壁可见急、慢性多种炎细胞浸润,肉芽肿及多核巨细胞,常有管壁破坏,弹性纤维断裂。治疗后的病例血管壁出现纤维化及管腔狭窄或闭塞。
除了以上典型的病理组织学表现外,WG可以有特殊或少见异型,如,弥漫性肺出血支气管中心性肉芽肿或闭塞性细支气管炎机化性肺炎,有时以以上病变为主要改变。

三、Churg-Strauss综合征
Churg-Strauss综合征(CSS)是一种以哮喘,外周血嗜酸细胞升高和血管炎三联征为特征的多系统疾病。过去也称为过敏性血管炎和肉芽肿病。由Churg和Strauss于1951年首次报道而得名。
1990年美国风湿协会提出css的诊断标准,其包括以下6条:
①哮喘;
②外周血嗜酸细 胞计数大于10%;
③单发或多发神经病变;
④影像学游走性肺部病变;
⑤鼻窦病变;
⑥活检 血管壁外嗜酸细胞浸润。
以上6条中有4条即可诊断为css。以上诊断标准对css诊断的敏感性为85%,特异性99.7%。目前,绝大多数css通过临床症状和实验室检查可明确诊断,有时经皮肤或神经肌肉活检,一般不需要进行肺活检。
css男女发病率大致相同,中位发病年龄为50岁,主要累及上呼吸道、肺、皮肤和周围神经系统,部分有心脏和肾脏累及。当伴有心脏和肾的累及常预后较差。实验室检查外周血嗜酸细胞升高,血沉加快及P-ANCA炎性及血清lgE升高。影像学表现为双肺胸膜下多发性实变或磨玻璃影。一般不形成空洞。
css的病程可分3期。
早期主要表现为过敏性鼻炎,哮喘;外周血嗜酸性粒细胞增多及嗜酸性粒细胞浸润性病变。
病变进一步进展进入血管期,此期患者出现血管炎的症状及体征。
最后为血管后期,患者有神经病变,高血压,持续性哮喘和过敏性鼻炎,心脏、肾及胃肠道累及。
css的典型病理组织学表现为哮喘性支气管炎,嗜酸细胞肺炎及坏死性血管炎和血管 外肉芽肿病变。css的血管炎可以累及动脉、静脉或毛细血管,血管壁可见较多嗜酸性粒细胞、淋巴细胞、上皮样细胞及多核巨细胞浸润,常见纤维素性坏死。
血管外可见栅栏状组织细胞及多核巨细胞组成的肉芽肿病变,肉芽肿的中心部外肉芽肿病变。css的血管炎可以累及动脉、静脉或毛见丰富的嗜酸性粒细胞及嗜酸性粒细胞核碎裂 这种病理改变也称为 "过敏性肉芽肿"。以上典型的病理改变并不一定在每例患者中均可见到特别是经过激素治疗的患者。

四、显微镜下多血管炎
显微镜下多血管炎(MPA), 以前称为显微镜下多动脉炎, 是一种病变局限于小动脉、 小静脉和毛细血管的系统性血管炎病变。其病变不仅累及动脉,还有静脉和毛细血管,
因此显微镜下多血管炎更符合其病理特点。 MPA临床上常表现为发热,体重下降, 口腔溃疡, 听力下降, 咽喉疼痛, 皮肤红斑及结节, 外周神经病变、 肾小球肾炎等症状。大约50%的患者可有肺部病变。
累及肺部可出现气短, 咳嗽,咯血, 胸痛。 约80%患 者ANCA阳性,常为P-ANCA阳性。 MPA患者的胸部CT上常表现为磨玻璃样阴影及肺泡填充影病变。 在病理组织学上,MPA表现为肺出血,肺泡腔内含铁血黄素沉着及中性粒细胞血管炎。
病变局限于小动脉、 小静脉和毛细血管。 病变区肺泡间隔增宽, 间隔内有较多中性粒细胞聚集, 毛细血管有纤维素性坏死和中性粒细胞浸润。

五、肺动脉高压
肺动脉高压是指静息时平均肺动脉压注25 mmHg。肺动脉高压按病因可以分为原发性(特发性)及继发性。 原发性肺动脉高压病因不明, 女性多见,多为散发性, 偶见家族性发病。
家族性肺动脉高压发病年龄较早,为一种常染色体显性遗传性疾病, 在其家族中有BMPR2 基因突变, 此基因位于2号染色体长臂31 -32区带(2q-31-32)。 继发性肺动脉高压,顾名思义, 是由于继发于其他疾病。 很多疾病可引起肺动脉高压,如结缔组织病、 先天性肺循环分流、 门脉高压、HIV感染、 药物等。
一般情况下, 根据临床表现及相关辅助检查,即可作出肺动脉高压的诊断。 多数情况下并不需要病理组织学检查。主要介绍肺动脉高压基本病理形态改变。 肺动脉高压的主要病理组织学改变表现在肺的肌性动脉和细动脉。 为了更好的帮助我们观察和分辨以上血管的层次及病变, 我们常借助一些特殊染色, 如弹性纤维染色就是一种常用的特染方法。 在病理组织学上,肺动脉高压的血管有以下6种病理变化:
1. 小动脉中膜肌层增生 肺组织内小动脉中膜平滑肌增生是肺动脉高压常见的病理改变。而且在轻、中度肺动脉高压情况下,中膜平滑肌增生的程度与肺动脉高压的程度呈正比。中膜平滑肌的增生常用中膜面积(或厚度)占血管管腔总面积(或直径)的百分比来表示。
不同管径的小动脉,其中膜所占的面积或比例不同。正常情况下,这一比值应小于20%。肺腺泡前肌性小动脉中膜占管腔的比例是1%~2%, 30%~300µm的小肌性动脉中膜的比例可高达5%。
2. 细动脉肌化 细动脉的肌化是另一个肺动脉高压的早期改变,即细动脉管壁出现中膜平滑肌层。 细动脉肌化后单纯从形态学上与肺小动脉无法区别, 但二者的位置不同, 小动脉伴随细支气管走行。 因此,细动脉的肌化表现为远离细支气管的 肺间质内出现肌性的小动脉样结构。
3. 动脉内膜增生和同心圈状层状纤维化 肺动脉高压时,动脉内膜由于细胞增生及纤维化而增厚, 二者常同时存在, 内膜显著增厚时, 可引起管腔的狭窄和闭塞。
4.丛状病变 丛状病变常见于中度肺动脉高压。常见于紧邻中膜和内膜增厚而阻塞的肺动脉远端的肌性小动脉,表现为动脉内膜内皮细胞异常增生,有多个不规则的管腔,形成肾小球样的结构。形态似血栓机化,但二者不同,丛状病变时有内弹力膜破坏。
5.纤维素样坏死及动脉炎 纤维素样坏死和动脉炎常见于中度肺动脉高压。表现为动脉管壁,特别是中膜坏死,弹力膜破坏,及纤维素样物沉积。
坏死性动脉炎的血管壁有炎细胞浸润,常为中性粒细胞,偶见淋巴细胞。
6. 血管扩张及血管瘤样病变 肺动脉管腔变薄、扩张、迂曲形成血管瘤样病变。